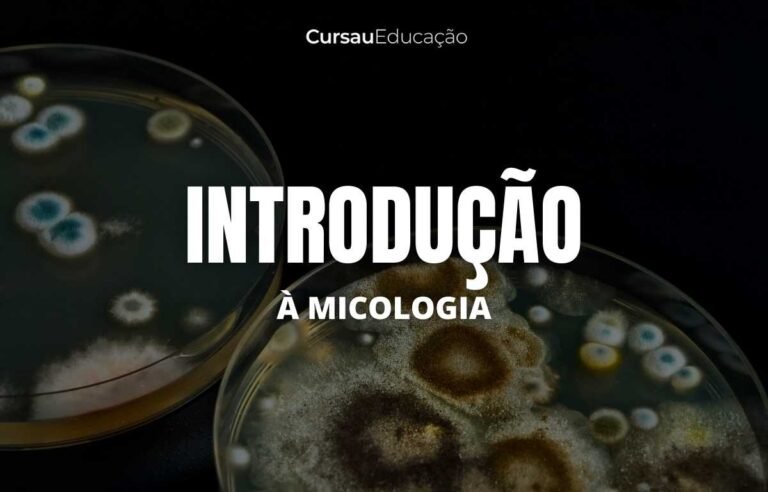
11
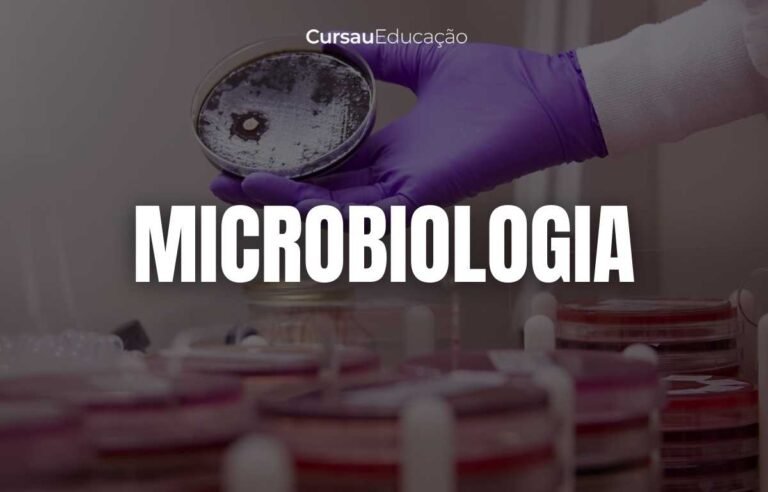
13
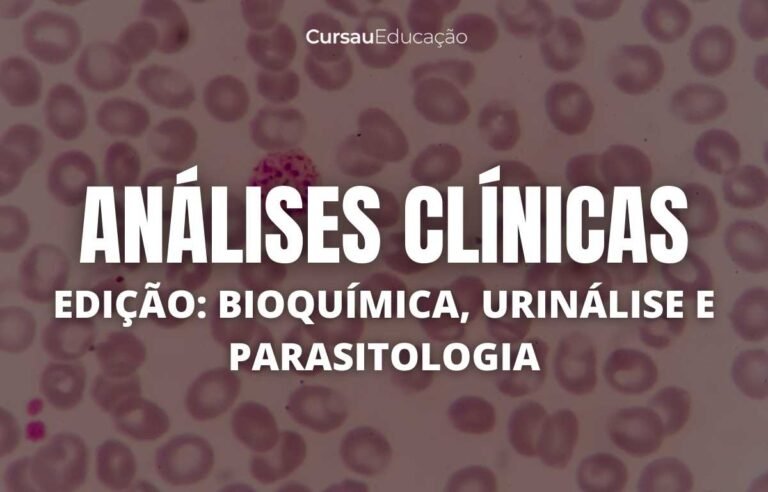
3
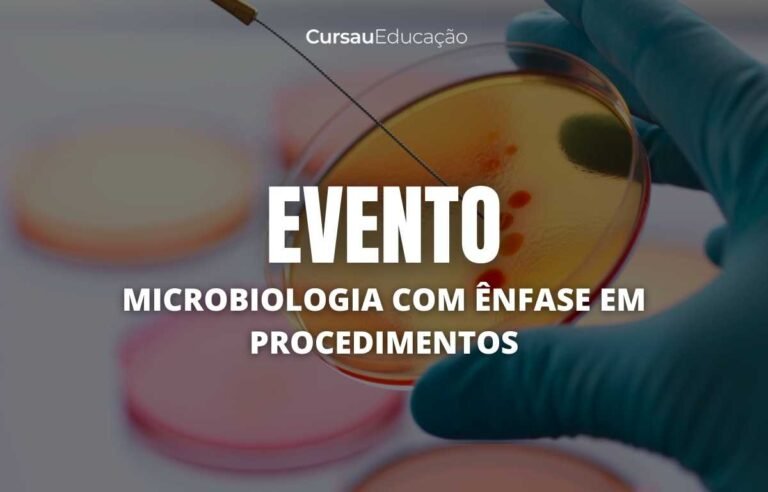
16

Com o conteúdo focado no que realmente importa e ministrado da forma correta, você irá aprender mais em menos tempo!
Nossos professores são especialistas, mestres, doutores e pós-doutorados que alimentam a plataforma com muito conteúdo de qualidade.

E para isso, iremos aumentar o seu índice de empregabilidade e a chance de você conseguir seu primeiro estágio ou emprego ainda este ano.
Com o conteúdo correto, ministrado por especialistas, fazendo com que você aprenda mais em menos tempo!
Temos mestres, doutores e pós-doutorados que alimentam a plataforma com muito conteúdo semanalmente.
Bioestatística
Curso rápido de biologia molecular
Introdução à bioinformática
Curso definição de palavras
Farmacologia
Embriologia
Fisiologia
Genética
Histologia
Introdução a bioquímica
Química básica
Patologia
Parasitologia
Microbiologia
Anatomia
Biologia molecular
Introdução a hematologia
Biossegurança
Anatomia da face
• Introdução a análises clínicas
• Curso de bioquímica clínica
• Curso de interpretação de exames
• Curso online de coleta de sangue
• Curso básico de leituras de lâminas
• Técnicas parasitológicas
• Hematologia
Experimentação in vivo e in vitro
Doenças tropicais e o impacto na saúde pública no Brasil
Acupuntura
Inglês
Laboratório na palma da mão
Análises clínicas na prática
Minicurso de leitura de lâminas de hematologia
Minicurso de uroanálise
Minicurso dos Principais Exames Laboratoriais na Estética
Minicurso: Como se preparar para um estágio em 2025 e fazer networking
Minicurso Guia Rápido após a Bancada: Interpretando Exames Laboratoriais
Minicurso Principais Testes e Conceitos em Genética e Biologia Molecular
Minicurso – Atuação do biomédico esteta: do mercado de trabalho aos procedimentos
Minicurso – Análise de casos reais: CSI no dia a dia
Curso de medicina legal
Minicurso – Procedimentos Estéticos na Prática: Full Face
Minicurso – Técnicas em reprodução humana assistida
Minicurso – Leitura de Lâminas hematológicas
Minicurso – Como interpretar exames laboratoriais em situações clínicas reais?
Treinamento em Sistema Vida
Trilha coleta de sangue
• Aula Prática de Análise de Líquor
• Aula Prática on-line de coleta de sangue
• Aula Prática de tipagem sanguínea
• Aula Prática Point of Care
Palestra internacional: a combinação de plasma gasoso e radioterapia em células cancerígenas
Palestra biomédico em Harvard
Saúde mental para começar 2022
Currículo e vagas de emprego na internet e fora dela
Síndrome do ovário policístico – SOP
Imagenologia
Como ser um ninja na biomedicina: gestão de carreira
Ozônioterapia
Iniciação científica: o primeiro passo para uma carreira acadêmica
Oficina de pipetagem by Eppendorf
Análise ambiental de água para consumo humano
Boas práticas de centrifugação
Como é a rotina de um estudante de pós-graduação no Brasil
Palestra – A importância da padronização da uroanálise
• Aulas ao vivo de diversas disciplinas da área da saúde.
• Aulas de Inglês
• Discussão de Casos Clínicos
• Grupo de pesquisa científica que ajuda na escrita de artigos
• PDFs
• Resumos
• Mapas mentais
• Apostilas
• Apoio acadêmico
• Vagas de emprego exclusivas
• Descontos em lojas parceiras
• Questões de concurso resolvidas
• Questões comentadas
• Caixinha de pergunta
• Explicações rápidas
• Ebooks
Para quem quer ser diferenciado e ter um currículo de destaque no mercado de trabalho
A plataforma possui biocoins que você pode acumular com interações e assistindo as aulas, subir de nível e trocar por prêmios!
ou à vista R$ 497,00/ano
Você tem 7 dias para conhecer a plataforma sem compromisso. Caso não atenda às suas expectativas, você pode solicitar o cancelamento e receber 100% do seu investimento de volta. Seus dados estão protegidos e sua compra é segura.
Tô super feliz por conseguir me inscrever dessa vez… me apaixonei desde o Workshop do ano passado 🥰
Eu amo a Plataforma Cursau. Toda a equipe super engajada, humanizada e muito unida. Isso é tão lindo de se ver, principalmente nos dias de hoje, onde há a falta de tudo no ser humano… Estou super feliz e satisfeita com a Plataforma que tem me ajudado muito em relação à minha segunda Graduação que é a Biomedicina.
Não se preocupe, seu acesso é liberado imediatamente após a confirmação do seu pagamento! Você receberá um e-mail com o link para acesso.
Caso tenha optado pelo pagamento no boleto, ele será compensado em até 3 dias úteis.
Sim, todos os cursos tem certificado que o aluno pode emitir ao concluir o curso dentro da plataforma.
Se você tiver problemas para acessar as aulas, entre em contato com nosso suporte: sac@cursaueducacao.com.br
Sim! A Plataforma Cursau possui um app que pode ser baixado gratuitamente na Play Store ou Apple Store.
Sim! No app da Plataforma Cursau você pode baixar as aulas e assistir quando estiver off-line.
Entre em contato com o suporte para processar a sua solicitação.
Entre em contato com o suporte para processar a sua solicitação.
ou à vista R$ 147,00
ou à vista R$ 147,00
ou à vista R$ 147,00